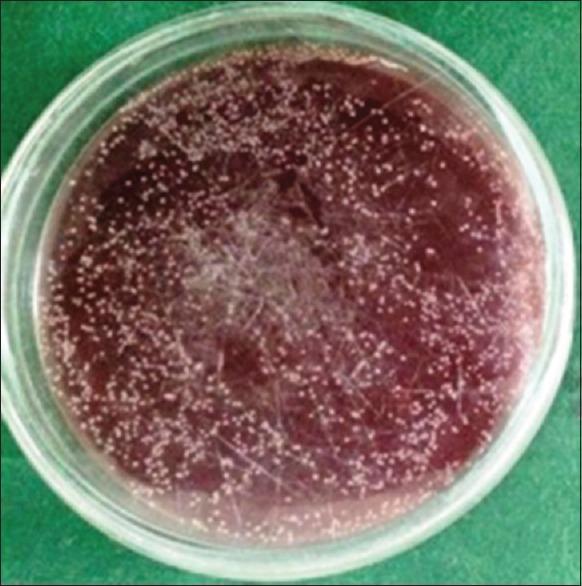
https://cdn.ncbi.nlm.nih.gov/pmc/blobs/bca1/6948065/5a6eb295105e/JOMFP-23-383-g001.jpg

对[具体提取物名称]提取物对[具体微生物种类1]、[具体微生物种类2]和[具体微生物种类3]的抗菌特性评估:一项[具体研究类型]研究。 (由于原文部分内容缺失,翻译可能不太完整准确,你可补充完整原文后再让我翻译。)
Evaluation of antimicrobial properties of and extracts on , species and : An study.
作者信息
Mahalakshmi Panjanathan, Rameshkumar Annasamy, Sudha Gunasekaran, Dineshkumar Thayalan, Vinoth Haridass, Malar Ada
机构信息
Department of Oral Pathology and Microbiology, SRM Dental College, Ramapuram, Chennai, Tamil Nadu, India.
Department of Oral and Maxillofacial Surgery, SRM Dental College, Ramapuram, Chennai, Tamil Nadu, India.
出版信息
J Oral Maxillofac Pathol. 2019 Sep-Dec;23(3):383-388. doi: 10.4103/jomfp.JOMFP_30_19.
INTRODUCTION
The Ayurvedic system of medicine is popular in India and has gone through various change and remains as the mainstay of medical relief to a large population. Dental caries is the one of the major issue in the recent time, and there is no definite caries prevention method so far apart from Topical fluoride application, regular oral hygiene measures, pit and fissure sealants and diet measure. In spite of the above mentioned preventive measures the people are still prone to dental caries. In order to find a better solution the present study evaluates the antimicrobial properties widely available and cost effective herbal extracts of Solanum xanthocarpum and Pistacia lentiscus extract on cariogenic oral microbial flora.
AIM
To Evaluate the Antimicrobial properties of Solanum xanthocarpum and Pistacia lentiscus extracts on cariogenic oral microbial flora.
METHODOLOGY
The antimicrobial properties of Solanum xanthocarpum and Pistacia lentiscus extracts on cariogenic oral microbial flora (streptococcus mutans, lactobacillus, actinomyces viscosus) by different culture techniques to estimate the zone of inhibition (well diffusion method) and minimum inhibitory concentration (tube dilution method).
RESULTS
The antimicrobial efficacy of Solanum xanthocarpum and Pistacia lentiscus on test bacteria were analysed using kurskal wallis test and values of 0.003 and 0.002 were obtained respectively, since the values were less than 0.005, indicating that both herbal products possess statistically significant antimicrobial properties.
CONCLUSION
The antimicrobial effects of the herbal extracts were almost on par with commercially available allopathic agents like chlorhexidine on oral cariogenic microbes. The efficacy should be further validated in a large scale studies and can be utilized for caries prevention in the form of mouth rinses, dentifrices and topical application in the future.
引言
阿育吠陀医学体系在印度很受欢迎,经历了各种变革,仍然是为大量人口提供医疗救助的主要支柱。龋齿是近年来的主要问题之一,除了局部应用氟化物、定期口腔卫生措施、窝沟封闭剂和饮食措施外,目前还没有明确的龋齿预防方法。尽管采取了上述预防措施,人们仍然容易患龋齿。为了找到更好的解决方案,本研究评估了广泛可用且具有成本效益的黄果茄和乳香黄连木提取物对致龋口腔微生物菌群的抗菌特性。
目的
评估黄果茄和乳香黄连木提取物对致龋口腔微生物菌群的抗菌特性。
方法
通过不同的培养技术(杯碟法测定抑菌圈,试管稀释法测定最低抑菌浓度)评估黄果茄和乳香黄连木提取物对致龋口腔微生物菌群(变形链球菌、乳酸杆菌、粘性放线菌)的抗菌特性。
结果
使用克鲁斯卡尔-沃利斯检验分析了黄果茄和乳香黄连木对测试细菌的抗菌效果,分别获得了0.003和0.002的值,由于这些值小于0.005,表明这两种草药产品均具有统计学上显著的抗菌特性。
结论
草药提取物的抗菌效果几乎与洗必泰等市售的对抗疗法药物对口腔致龋微生物的效果相当。其疗效应在大规模研究中进一步验证,未来可制成漱口水、牙膏和局部应用制剂用于预防龋齿。